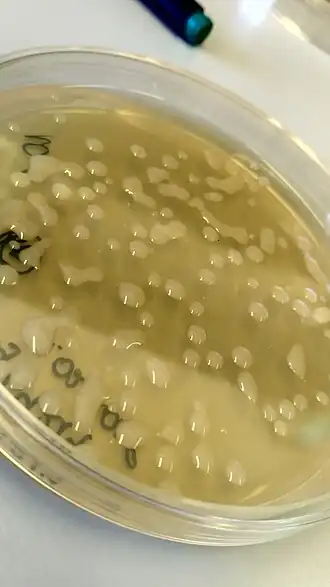
Description de cette image, également commentée ci-après

Paracoccus
| Domaine | Bacteria |
|---|---|
| Phylum | Pseudomonadota |
| Classe | Alphaproteobacteria |
| Ordre | Rhodobacterales |
| Famille | Paracoccaceae |
Paracoccus est un genre de bactéries gram négatives de la famille des Paracoccaceae.
Historique
Les Paracoccus ont été décrites comme un nouveau genre bactérien lors du rejet du genre Hydrogenomonas lequel était un genre historique créé en 1909 par Sigurd Orla-Jensen[1].
Description
Les Paracoccus sont des bactéries à coloration de Gram négative. Elles ne forment pas de spores et sont non mobiles[2]. Elles sont aérobies strictes (sauf si le milieu contient du nitrate). Le métabolisme est respiratoire et non fermentatif. Ces bactéries ont des réactions positives pour les tests catalase et oxydase mais négatives pour l'arginine dihydrolase[2]. Elles sont hétérotrophes mais elles peuvent être autotrophes facultatives si cela s'accompagne d'une oxydation aérobie d'hydrogène comme source d'énergie[2].
Le contenu en guanine plus cytosine est de 62 à 67 %[2].
Taxonomie
Le nom correct complet (avec auteur) de ce taxon est Paracoccus Davis 1969 (pour Diana Helen Davis)[3].
L'espèce type est : Paracoccus denitrificans (Beijerinck & Minkman 1910) Davis 1969[3].
Paracoccus a pour synonyme[3] :
- Thiosphaera Robertson & Kuenen 1984
Étymologie
L'étymologie du nom générique est Pa.ra.coc’cus. Gr. prep. para, à proximité de, ressemblant; N.L. masc. n. coccus, un grain; du nom masculin grec kokkos, grain; N.L. masc. n. Paracoccus, comme un coccus[3].
Liste des espèces
Selon la LPSN (20 juillet 2024)[3], le genre Paracoccus comprend 86 espèces publiées de manière valide et au nom correct :
- Paracoccus acridae Zhang et al. 2016
- Paracoccus aeridis Rai et al. 2020
- Paracoccus aerius Xue et al. 2017
- Paracoccus aerodenitrificans Zhang et al. 2023
- Paracoccus aestuarii Roh et al. 2009
- Paracoccus aestuariivivens Park et al. 2016
- Paracoccus albicereus He et al. 2023
- Paracoccus albus Zhang et al. 2023
- Paracoccus alcaliphilus Urakami et al. 1989
- Paracoccus alimentarius Kim et al. 2018
- Paracoccus alkanivorans Zhang et al. 2020
- Paracoccus alkenifer Lipski et al. 1998
- Paracoccus aminophilus Urakami et al. 1990
- Paracoccus aminovorans Urakami et al. 1990
- Paracoccus amoyensis Lyu et al. 2021
- Paracoccus angustae Sun et al. 2015
- Paracoccus aurantiacus Ye et al. 2020
- Paracoccus bengalensis Ghosh et al. 2006
- Paracoccus caeni Lee et al. 2011
- Paracoccus carotinifaciens Tsubokura et al. 1999
- Paracoccus cavernae Dominguez-Moñino et al. 2016
- Paracoccus chinensis Li et al. 2009
- Paracoccus communis Poroshina et al. 2014
- Paracoccus contaminans Kämpfer et al. 2016
- Paracoccus denitrificans (Beijerinck & Minkman 1910) Davis 1969
- Paracoccus endophyticus Zhang et al. 2019
- Paracoccus everestensis Cui et al. 2022
- Paracoccus fistulariae Kim et al. 2010
- Paracoccus fontiphilus Sheu et al. 2018
- Paracoccus haematequi Kämpfer et al. 2019
- Paracoccus haeundaensis Lee et al. 2004
- Paracoccus halophilus Liu et al. 2008
- Paracoccus halotolerans Meng et al. 2019
- Paracoccus hibisci Yan et al. 2017
- Paracoccus hibiscisoli Lin et al. 2017
- Paracoccus homiensis Kim et al. 2006
- Paracoccus huijuniae Sun et al. 2013
- Paracoccus isoporae Chen et al. 2011
- Paracoccus kocurii Ohara et al. 1990
- Paracoccus kondratievae Doronina & Trotsenko 2001
- Paracoccus koreensis La et al. 2005
- Paracoccus laeviglucosivorans Nakamura 2015
- Paracoccus liaowanqingii Li et al. 2020
- Paracoccus lichenicola Lang et al. 2023
- Paracoccus limosus Lee & Lee 2013
- Paracoccus litorisediminis Park et al. 2017
- Paracoccus luteus Ming et al. 2020
- Paracoccus lutimaris Jung et al. 2014
- Paracoccus mangrovi Chen et al. 2017
- Paracoccus marcusii Harker et al. 1998
- Paracoccus marinaquae Xue et al. 2023
- Paracoccus marinus Khan et al. 2008
- Paracoccus methylovorus Timsy et al. 2022
- Paracoccus methylutens Doronina et al. 1998
- Paracoccus niistensis Dastager et al. 2012
- Paracoccus nototheniae Kämpfer et al. 2019
- Paracoccus onchidii Xu et al. 2024
- Paracoccus onubensis Gutierrez-Patricio et al. 2021
- Paracoccus pacificus Zhang et al. 2015
- Paracoccus panacisoli Nguyen et al. 2015
- Paracoccus pantotrophus (Robertson & Kuenen 1984) Rainey et al. 1999
- Paracoccus rhizosphaerae Kämpfer et al. 2012
- Paracoccus salipaludis Dong et al. 2018
- Paracoccus saliphilus Wang et al. 2009
- Paracoccus salsus Gao et al. 2022
- Paracoccus sanguinis McGinnis et al. 2015
- Paracoccus sediminicola Zhang et al. 2023
- Paracoccus sediminilitoris Wei et al. 2019
- Paracoccus sediminis Pan et al. 2014
- Paracoccus seriniphilus Pukall et al. 2003
- Paracoccus shanxieyensis Dong et al. 2023
- Paracoccus simplex Doronina et al. 2020
- Paracoccus solventivorans Siller et al. 1996
- Paracoccus sordidisoli Singh et al. 2017
- Paracoccus sphaerophysae Deng et al. 2011
- Paracoccus stylophorae Sheu et al. 2011
- Paracoccus subflavus Zhang et al. 2019
- Paracoccus sulfuroxidans Liu et al. 2006
- Paracoccus suum Heo et al. 2019
- Paracoccus tegillarcae Lee et al. 2019
- Paracoccus thiocyanatus Katayama et al. 1996
- Paracoccus tibetensis Zhu et al. 2013
- Paracoccus versutus (Harrison 1983) Katayama et al. 1996
- Paracoccus xiamenensis Lyu et al. 2020
- Paracoccus yeei corrig. Daneshvar et al. 2003, parfois publiée de manière erronée sous Paracoccus yeeii.
- Paracoccus zeaxanthinifaciens Berry et al. 2003
Espèces non valides
Selon la LPSN (20 juillet 2024)[3], on retrouve plusieurs espèces publiées de manière non valide et au nom préféré (mais non correct) :
- "Paracoccus aquimaris" Kim et Lee 2015
- "Paracoccus beibuensis" Zheng et al. 2011
- "Paracoccus benzoatiresistens" Mu et al. 2024
- "Paracoccus binzhouensis" Wang et al. 2021
- "Paracoccus bogoriensis" Osanjo et al. 2009
- "Paracoccus ferrooxidans" Kumaraswamy et al. 2006
- "Paracoccus gahaiensis" Zhang et al. 2016
- "Paracoccus indicus" Lin et al. 2019
- "Paracoccus jeotgali" Kim et al. 2019
- "Paracoccus maritimus" Yu et al. 2024
- "Paracoccus mutanolyticus" Buddana et al. 2016
- "Paracoccus oceanense" Fu et al. 2011
- "Paracoccus pueri" Wang et al. 2018
- "Paracoccus ravus" Yoon et al. 2019
- "Paracoccus schoinia" Takaichi et al. 2006
- "Paracoccus shandongensis" Gong et al. 2021
- "Paracoccus siganidrum" Liu et al. 2013
- "Paracoccus thiophilus" Doronina et al. 2002
- "Paracoccus zhejiangensis" Wu et al. 2013
Espèces synonymes
Selon la LPSN (20 juillet 2024)[3], deux espèces ont été synonymisées et déplacées dans d'autres genres bactériens, Halomonas et Methylarcula :
- "Paracoccus halodenitrificans"(Robinson et Gibbons 1952) Davis 1969 désormais renommée Halomonas halodenitrificans
- "Paracoccus methylarcula"Doronina 2023 désormais renommée Methylarcula marina Doronina et al. 2000
Références
Bibliographie
- Publication originale (en) Diana H. Davis, Michael Doudoroff, Roger Y. Stanier et Manley Mandel, « Proposal to reject the genus Hydrogenomonas: taxonomic implications. », International Journal of Systematic Bacteriology, vol. 19, no 4, , p. 375-390 (DOI 10.1099/00207713-19-4-375)
Liens externes
- (en) Myers, P. et al., Animal Diversity Web : Paracoccus, 2024 (consulté le )
- (en) BioLib : Paracoccus Davis, 1969 (consulté le )
- (en) Catalogue of Life : Paracoccus (consulté le )
- (fr + en) GBIF : Paracoccus Ezzat & McConnell, 1956 (consulté le )
- (fr) INPN : Paracoccus Davis, 1969 (TAXREF) (consulté le )
- (fr + en) ITIS : Paracoccus Davis, 1969 emend. Liu et al., 2008 (consulté le )
- (en) LPSN : Paracoccus Davis 1969 (consulté le )
- (en) NCBI : Paracoccus (taxons inclus) (consulté le )
- (en) OEPP : Paracoccus (consulté le )
- (en) Taxonomicon : Paracoccus Davis 1969 (Approved Lists 1980) (consulté le )
- (en) WoRMS : Paracoccus Davis, 1969 (+ liste espèces) (consulté le )
- Portail de la microbiologie